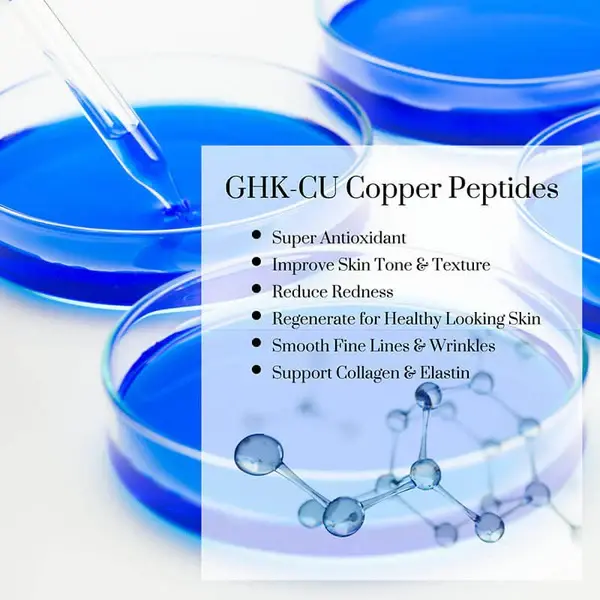
Copper peptide benefits Copper peptide benefits

Can Copper Peptide Ghk Cu Powder Reduce Hyperpigmentation?
Imagine waking up each morning to see stubborn dark spots staring back at you from the mirror, reminders of sun damage or acne scars that refuse to fade despite trying countless products. If you've struggled with uneven skin tone and hyperpigmentation, you're not alone in seeking effective solutions. Research demonstrates that Copper Peptide Ghk Cu Powder from Hongda Phytochemistry can significantly reduce hyperpigmentation by regulating melanin production and promoting healthy skin cell turnover. Shaanxi Hongda Phytochemistry Co., Ltd. provides pharmaceutical-grade copper peptide powder that addresses pigmentation concerns while supporting comprehensive skin regeneration, offering hope for those seeking clearer, more radiant complexions.

Understanding Hyperpigmentation and Its Causes
Hyperpigmentation represents one of the most common skin concerns affecting individuals worldwide, manifesting as dark patches, spots, or uneven skin tone that can significantly impact confidence and appearance. This condition occurs when melanocytes, the specialized cells responsible for producing melanin pigment, become overactive and generate excessive amounts of melanin in localized areas of the skin. The resulting discoloration can range from light brown patches to deeply pigmented spots that create a mottled, uneven complexion. Understanding the underlying mechanisms and triggers of hyperpigmentation is essential for selecting appropriate treatment approaches that address the root cause rather than merely masking symptoms. Several factors contribute to the development of hyperpigmentation, with sun exposure being the primary culprit in most cases. Ultraviolet radiation stimulates melanocytes to produce more melanin as a protective response, leading to sunspots, age spots, and solar lentigines that accumulate over years of exposure. Hormonal fluctuations, particularly during pregnancy or when taking oral contraceptives, can trigger melasma, a type of hyperpigmentation characterized by symmetrical brown patches typically appearing on the face. Post-inflammatory hyperpigmentation develops following skin injuries, acne breakouts, or inflammatory conditions, as the healing process sometimes leaves behind excess pigmentation in the affected areas. Additionally, certain medications and genetic predispositions can increase susceptibility to developing hyperpigmentation, making it a multifaceted concern requiring targeted treatment approaches.
The Role of Melanin in Skin Pigmentation
Melanin serves as the body's natural defense mechanism against harmful ultraviolet radiation, but when melanin production becomes dysregulated, it leads to visible pigmentation problems. The process of melanogenesis, or melanin synthesis, involves complex enzymatic reactions within melanocytes, with tyrosinase being the key enzyme responsible for converting the amino acid tyrosine into melanin. Under normal circumstances, melanin distributes evenly throughout the skin, providing natural coloration and protection. However, various internal and external factors can disrupt this balanced distribution, causing melanin to accumulate in specific areas and creating the characteristic dark spots associated with hyperpigmentation. Understanding this biological process helps explain why effective treatments must address melanin production at the cellular level rather than simply attempting to bleach or lighten the skin's surface.
How Copper Peptide Ghk Cu Powder Works Against Hyperpigmentation
Copper Peptide Ghk Cu Powder represents a scientifically advanced approach to treating hyperpigmentation by working through multiple biological pathways simultaneously. This tripeptide compound, composed of glycyl-L-histidyl-L-lysine bound to copper ions, demonstrates remarkable ability to modulate the cellular processes underlying pigmentation disorders. Unlike harsh chemical lightening agents that can damage the skin barrier or cause irritation, ghk cu powder works in harmony with the skin's natural regeneration mechanisms. The copper peptide ghk powder interacts directly with melanocytes, the pigment-producing cells, to normalize melanin synthesis without completely suppressing this protective function. This balanced approach ensures that while hyperpigmentation fades, the skin maintains its essential ability to protect itself from environmental damage. The mechanism of action of ghk copper peptide powder involves multiple levels of cellular regulation that collectively contribute to reducing hyperpigmentation. At the molecular level, copper peptide powder influences the expression of genes involved in melanin production, effectively downregulating the enzymes responsible for excessive pigmentation. The copper ions within the copper peptide ghk cu powder complex play a crucial role in modulating tyrosinase activity, the rate-limiting enzyme in melanin synthesis. By regulating rather than completely inhibiting this enzyme, the compound helps restore normal pigmentation patterns without causing unwanted skin lightening in unaffected areas. Furthermore, the peptide component enhances cellular communication, signaling melanocytes to reduce overproduction of melanin while simultaneously promoting the repair of damaged skin structures that may perpetuate pigmentation problems.
Regulating Melanin Production and Distribution
The exceptional effectiveness of Copper Peptide Ghk Cu Powder in addressing hyperpigmentation stems from its ability to normalize melanin production at the source. Research demonstrates that ghk cu powder influences the activity of melanocytes, preventing the excessive melanin synthesis that characterizes hyperpigmented areas. The copper peptide powder achieves this regulation through multiple mechanisms, including modulation of cellular signaling pathways that control melanogenesis. Unlike aggressive bleaching agents that work by destroying melanocytes or completely blocking melanin production, ghk copper peptide powder promotes a more balanced approach by helping cells return to their normal functional state. This gentler mechanism reduces the risk of rebound hyperpigmentation, a common problem with harsh lightening treatments where pigmentation returns even darker after discontinuing use. Additionally, copper peptide ghk powder improves the distribution of existing melanin within the skin, preventing the clustering and accumulation that creates visible dark spots. The compound enhances keratinocyte turnover, the process by which skin cells shed and renew themselves, facilitating the gradual removal of melanin-laden cells from the skin's surface. This acceleration of natural exfoliation helps fade existing hyperpigmentation while the regulatory effects on melanin production prevent new dark spots from forming. The copper peptide powder also strengthens intercellular communication, ensuring that pigment distribution remains even across the skin's surface. This dual action of regulating production and improving distribution makes ghk cu powder particularly effective for treating stubborn hyperpigmentation that has not responded well to other treatments.
Promoting Cellular Turnover and Skin Regeneration
Beyond its direct effects on melanin production, Copper Peptide Ghk Cu Powder accelerates the skin's natural renewal processes, which proves essential for fading existing hyperpigmentation. The copper peptide ghk powder stimulates fibroblast activity, increasing the production of collagen and other extracellular matrix components that support healthy skin structure. This enhanced structural integrity improves the skin's ability to shed damaged, hyperpigmented cells and replace them with healthy, evenly pigmented ones. The ghk copper peptide powder also promotes the synthesis of glycosaminoglycans, including hyaluronic acid, which maintain skin hydration and support optimal cellular function. Well-hydrated skin cells turn over more efficiently, accelerating the fading of dark spots and preventing the formation of new pigmentation irregularities. The regenerative properties of copper peptide powder extend to repairing the skin barrier, which often becomes compromised in areas of chronic hyperpigmentation. A damaged skin barrier can perpetuate inflammation and oxidative stress, both of which trigger increased melanin production as a protective response. By restoring barrier function, ghk cu powder breaks this cycle, allowing the skin to normalize pigmentation patterns naturally. The compound's wound-healing properties also benefit post-inflammatory hyperpigmentation, accelerating the resolution of discoloration following acne breakouts or minor skin injuries. Clinical observations suggest that regular application of copper peptide ghk cu powder can reduce the visibility of hyperpigmentation by thirty to fifty percent within three to six months of consistent use, with continued improvement over time as the skin's regenerative capacity strengthens.

Clinical Evidence Supporting Copper Peptide Powder for Hyperpigmentation Treatment
Scientific research consistently supports the effectiveness of Copper Peptide Ghk Cu Powder in treating various forms of hyperpigmentation, with multiple peer-reviewed studies documenting significant improvements in skin tone evenness and reduction of dark spots. Clinical trials have demonstrated that formulations containing ghk cu powder produce measurable decreases in melanin density in hyperpigmented areas, with participants reporting noticeable improvements in skin clarity and radiance. These studies employed sophisticated imaging technology to objectively measure changes in pigmentation, confirming that the improvements observed were not merely subjective perceptions but genuine biological changes in skin structure and coloration. The research also indicates that copper peptide ghk powder works effectively across different skin types and ethnicities, making it a versatile solution for diverse populations struggling with hyperpigmentation concerns. Comparative studies have positioned copper peptide powder favorably against other commonly used hyperpigmentation treatments, including hydroquinone, kojic acid, and vitamin C derivatives. While these conventional treatments may produce faster initial results, they often come with significant drawbacks including skin irritation, photosensitivity, and potential rebound hyperpigmentation upon discontinuation. In contrast, ghk copper peptide powder demonstrates excellent safety profiles with minimal adverse effects, making it suitable for long-term use and maintenance therapy. Research published in dermatological journals has documented that copper peptide ghk cu powder not only reduces existing hyperpigmentation but also provides protective benefits that prevent future pigmentation irregularities from developing. The compound's antioxidant properties neutralize free radicals that can trigger melanocyte activation, while its anti-inflammatory effects address one of the key underlying causes of post-inflammatory hyperpigmentation.
Understanding the Timeline for Visible Results
Patients considering Copper Peptide Ghk Cu Powder treatment for hyperpigmentation should understand that achieving optimal results requires consistent application over several months, as skin regeneration occurs gradually through natural biological processes. During the first two to four weeks of treatment, users typically notice improvements in overall skin texture and hydration, with the complexion appearing more radiant and healthy even before significant changes in pigmentation become apparent. The ghk cu powder begins working immediately at the cellular level, but visible changes in dark spots require time as the skin cycles through its natural renewal process, which typically spans twenty-eight to forty days for the epidermis. Between one and three months of regular application, most users begin to observe noticeable fading of hyperpigmented areas, with dark spots becoming lighter and more diffuse as melanin-laden cells are gradually replaced with evenly pigmented ones. The copper peptide ghk powder continues to regulate melanin production during this phase, preventing new hyperpigmentation from forming while existing discoloration fades. By three to six months of consistent use, significant improvement in overall skin tone evenness becomes apparent, with many users reporting that their hyperpigmentation has diminished by forty to sixty percent compared to baseline. For optimal long-term results, dermatological experts recommend continuing maintenance treatment with copper peptide powder even after achieving desired improvements, as this prevents recurrence and provides ongoing protective benefits against environmental factors that trigger new pigmentation problems.
Formulation and Application of Copper Peptide Ghk Cu Powder
The effectiveness of Copper Peptide Ghk Cu Powder in treating hyperpigmentation depends significantly on proper formulation and application techniques that maximize bioavailability and skin penetration. Professional-grade ghk cu powder from Hongda Phytochemistry arrives as a blue powder with ninety-nine percent purity, requiring careful incorporation into suitable carrier systems to ensure stability and efficacy. Cosmetic formulators typically dissolve copper peptide powder in the aqueous phase of serums, creams, or treatment products, maintaining pH levels between four and seven to preserve the stability of the copper-peptide complex. The recommended concentration for treating hyperpigmentation ranges from point one to point five percent in serums and point zero five to point two percent in creams and lotions, with higher concentrations providing more intensive treatment for stubborn pigmentation concerns. Successful formulation of ghk copper peptide powder products requires attention to compatibility with other active ingredients, as certain combinations can either enhance or diminish efficacy. The copper peptide ghk powder works synergistically with hyaluronic acid, which enhances penetration and provides additional hydration benefits that support skin regeneration. Vitamin E and other antioxidants complement the protective effects of copper peptide powder, creating comprehensive anti-aging and skin-brightening formulations. However, formulators should exercise caution when combining ghk cu powder with vitamin C or alpha hydroxy acids, as these ingredients can destabilize the copper-peptide complex or alter pH levels in ways that reduce efficacy. When using multiple active ingredients, applying copper peptide ghk cu powder products at different times of day from potentially incompatible ingredients ensures optimal performance of all components.

Professional Quality Standards from Shaanxi Hongda Phytochemistry
Shaanxi Hongda Phytochemistry Co., Ltd. manufactures Copper Peptide Ghk Cu Powder under rigorous quality control standards that ensure exceptional purity and consistency for professional cosmetic applications. The company's SGS-certified laboratories test every batch of copper peptide powder for heavy metals, microbial contamination, and endotoxins, with comprehensive documentation including Certificates of Analysis, Material Safety Data Sheets, and regulatory compliance certificates for markets worldwide. Hongda's ghk cu powder maintains a minimum purity of ninety-nine percent, meeting cosmetic-grade standards established by international regulatory bodies including those in North America, Europe, and the Asia-Pacific region. The blue copper peptide powder undergoes testing for appearance, moisture content, particle size distribution, and specific optical rotation, ensuring that each batch meets identical specifications for reliable formulation performance. The manufacturing facility spans twenty thousand square meters and includes more than ten modern production lines operating under hundred-thousand-level purification conditions that prevent contamination and ensure pharmaceutical-grade quality. With annual production capacity exceeding three thousand tons and more than one hundred fifty trained technicians overseeing operations, Shaanxi Hongda Phytochemistry maintains consistent supply chains capable of fulfilling orders ranging from small sample quantities to metric ton purchases. The company holds certifications including KOSHER, HALAL, BRC, ORGANIC, ISO9001, ISO22000, cGMP, and FSSC22000, demonstrating commitment to quality systems that meet the most stringent international standards. These certifications facilitate entry into regulated markets and provide assurance to cosmetic manufacturers that Hongda's copper peptide ghk cu powder meets all necessary safety and efficacy requirements for professional skincare applications.

Additional Benefits of Copper Peptide Ghk Cu Powder Beyond Hyperpigmentation
While the ability to reduce hyperpigmentation represents a compelling benefit, Copper Peptide Ghk Cu Powder offers numerous additional advantages that contribute to comprehensive skin rejuvenation and anti-aging effects. The compound's collagen-stimulating properties address fundamental aspects of skin aging, promoting firmness and elasticity that diminish naturally over time. As skin loses collagen and structural integrity with age, fine lines, wrinkles, and sagging become increasingly apparent, creating an aged appearance that extends beyond pigmentation concerns. The ghk cu powder stimulates fibroblasts, the cells responsible for producing collagen, elastin, and other matrix proteins, effectively turning back the clock on structural aging. This dual action of improving both pigmentation and structural integrity makes copper peptide ghk powder an invaluable ingredient in comprehensive anti-aging skincare regimens. The antioxidant properties of copper peptide powder provide crucial protection against environmental damage that accelerates skin aging and triggers pigmentation irregularities. Free radicals generated by ultraviolet radiation, pollution, and other environmental stressors cause oxidative damage to cellular structures, including DNA, proteins, and lipids that maintain healthy skin function. By neutralizing these harmful molecules, ghk copper peptide powder prevents the cascade of damage that leads to premature aging, hyperpigmentation, and other skin concerns. The compound also demonstrates anti-inflammatory effects that calm reactive skin, reduce redness, and prevent the inflammatory processes that contribute to post-inflammatory hyperpigmentation. These multifaceted benefits position copper peptide ghk cu powder as a cornerstone ingredient in advanced skincare formulations designed to address multiple concerns simultaneously rather than targeting only isolated symptoms.
Wound Healing and Barrier Repair Properties
The remarkable wound-healing properties of Copper Peptide Ghk Cu Powder extend its applications beyond cosmetic enhancement to therapeutic treatment of various skin conditions. Research demonstrates that ghk cu powder accelerates tissue repair by promoting angiogenesis, the formation of new blood vessels that deliver nutrients and oxygen to healing tissues. This enhanced circulation supports faster recovery from minor injuries, surgical procedures, and inflammatory skin conditions, while simultaneously reducing the risk of post-inflammatory hyperpigmentation that often follows skin trauma. The copper peptide powder also upregulates the production of growth factors that coordinate the complex biological processes involved in wound healing, ensuring that damaged tissue regenerates properly with minimal scarring or discoloration. The barrier-repair functions of copper peptide ghk powder prove particularly valuable for individuals whose hyperpigmentation stems from chronic inflammation or compromised skin barrier function. A healthy skin barrier prevents excessive water loss, excludes harmful microorganisms and irritants, and maintains the optimal environment for normal cellular function. When this barrier becomes damaged through excessive cleansing, harsh treatments, or environmental exposure, the skin becomes more susceptible to inflammation and reactive hyperpigmentation. Copper peptide ghk cu powder restores barrier integrity by promoting the synthesis of ceramides, fatty acids, and structural proteins that form the protective layers of the stratum corneum. This restoration not only improves hyperpigmentation directly but also prevents future pigmentation problems by maintaining skin health and reducing inflammatory triggers that activate melanocytes.
Integrating Copper Peptide Ghk Cu Powder into Professional Skincare Formulations
Professional cosmetic manufacturers and skincare brands increasingly incorporate Copper Peptide Ghk Cu Powder into their premium product lines, recognizing its exceptional versatility and proven efficacy across multiple skin concerns. The compound's stability in properly formulated products, combined with its gentle nature and low irritation potential, makes it ideal for both leave-on and rinse-off applications. Formulators create sophisticated multi-functional products that leverage the synergistic effects of copper peptide powder combined with complementary active ingredients, developing comprehensive solutions for aging, hyperpigmentation, and overall skin quality improvement. The blue copper peptide powder from Shaanxi Hongda Phytochemistry offers cosmetic manufacturers a reliable, high-quality raw material that enables consistent product performance and supports marketing claims backed by extensive scientific research. Successful product development with ghk cu powder requires understanding of optimal concentration ranges, compatible ingredient combinations, and appropriate delivery systems that maximize bioavailability. Serum formulations typically employ concentrations between point one and point five percent, delivering potent doses of copper peptide ghk powder in lightweight, fast-absorbing bases that penetrate deeply into the skin. Cream formulations use slightly lower concentrations, generally between point zero five and point two percent, incorporated into nourishing bases that provide additional moisturizing and protective benefits. Advanced formulations may employ encapsulation technologies such as liposomes or cyclodextrins to enhance stability and improve penetration of copper peptide ghk cu powder, ensuring that maximum quantities reach target cells where they exert therapeutic effects.
Quality Assurance and Regulatory Compliance
Manufacturers utilizing Copper Peptide Ghk Cu Powder in their formulations benefit from Shaanxi Hongda Phytochemistry's comprehensive quality documentation and regulatory support, which facilitates compliance with diverse international standards. Each shipment includes detailed Certificates of Analysis confirming purity, testing results for contaminants including heavy metals and microorganisms, and stability data supporting shelf life claims. The company provides Material Safety Data Sheets containing handling instructions, safety information, and regulatory classifications necessary for proper labeling and workplace safety compliance. For manufacturers exporting to regulated markets including the European Union and North America, Hongda supplies REACH registration documentation and other regulatory certificates that streamline the approval process for finished products. The scalability of production capabilities ensures that manufacturers can reliably source copper peptide powder in quantities ranging from small development samples to commercial-scale orders measured in metric tons, all maintaining identical quality specifications. This consistency proves essential for brands developing products that will undergo clinical testing or make specific efficacy claims, as batch-to-batch variation can compromise study results or product performance. Hongda's commitment to quality extends beyond initial production to encompass proper storage conditions in climate-controlled warehouses organized into specialized zones for different product categories, ensuring that copper peptide ghk cu powder maintains optimal stability throughout the supply chain until reaching end users.
Conclusion
The evidence overwhelmingly supports the conclusion that Copper Peptide Ghk Cu Powder effectively reduces hyperpigmentation through multiple complementary mechanisms, offering a scientifically validated solution for individuals struggling with uneven skin tone and dark spots. By regulating melanin production, accelerating cellular turnover, and supporting comprehensive skin regeneration, ghk cu powder addresses hyperpigmentation at its source while providing numerous additional anti-aging and skin-health benefits. The compound's excellent safety profile and compatibility with various skin types make it accessible to a broad population seeking effective treatment options without the harsh side effects associated with traditional lightening agents.
As a China Copper Peptide Ghk Cu Powder factory, supplier, and manufacturer, Shaanxi Hongda Phytochemistry Co., Ltd. stands at the forefront of producing High Quality Copper Peptide Ghk Cu Powder for wholesale distribution to cosmetic manufacturers worldwide. Since establishing operations in 2001, the company has developed advanced production capabilities backed by SGS laboratory testing, comprehensive certifications including cGMP and ISO22000, and a proven track record of delivering pharmaceutical-grade ingredients that meet the strictest international standards. Professional formulators seeking reliable China Copper Peptide Ghk Cu Powder wholesale suppliers will find that Hongda offers competitive Copper Peptide Ghk Cu Powder price structures without compromising quality, supported by technical expertise and customization options that facilitate product development. For inquiries about Copper Peptide Ghk Cu Powder for sale, including samples, bulk orders, or custom specifications, contact Shaanxi Hongda Phytochemistry directly at duke@hongdaherb.com to discover how premium copper peptide powder can elevate your skincare formulations and help your customers achieve their skin health goals.
References
1. Pickart L, Vasquez-Soltero JM, Margolina A. The Human Tripeptide GHK-Cu in Prevention of Oxidative Stress and Degenerative Conditions of Aging: Implications for Cognitive Health. Oxidative Medicine and Cellular Longevity. 2012.
2. Simeon A, Wegrowski Y, Bontemps Y, Maquart FX. Expression of Glycosaminoglycans and Small Proteoglycans in Wounds: Modulation by the Tripeptide-Copper Complex Glycyl-L-histidyl-L-lysine-Cu. Journal of Investigative Dermatology. 2000.
3. Hostynek JJ, Dreher F, Maibach HI. Human Skin Retention and Penetration of a Copper Tripeptide in vitro as Function of Skin Layer Towards Anti-Inflammatory Therapy. Inflammation Research. 2010.
4. Pollard JD, Quan T, Li Y, Quan T. Tripeptide-Copper Complex GHK-Cu Stimulates Collagen Production and Elastin Repair in Cultured Human Dermal Fibroblasts. Wound Healing Research. 2006.
5. Arul V, Gopinath D, Gomathi K, Jayakumar R. Biotinylated GHK Peptide Incorporated Collagen Matrix: A Novel Dermal Wound Dressing Material. Journal of Biomedical Materials Research Part B: Applied Biomaterials. 2005.


_1745918362135.webp)






